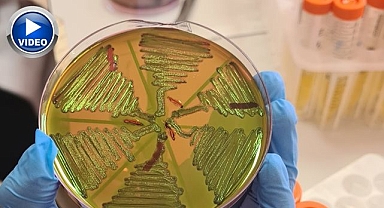
Aman dikkat! Çiğ süt tehlike saçıyor

Spor Toto 1. Ligin 10’ncu haftasında oynanacak olan maçların hakemleri belli oldu. Yarın saat 16:00’da oynanacak olan Altay-Erzurumspor maçında Furkan Aksuoğlu düdük çalacak.
Muhammet TARHAN/PUSULA
Spor Toto 1. Ligin 10’ncu haftasında oynanacak olan maçların hakemleri belli oldu.
Türkiye Futbol Federasyonu (TFF) Merkez Hakem Kurulu(MHK) Erzurumspor’un yarın saat 16:00’da deplasmanda oynayacağı Altay maçına orta hakem olarak Furkan Aksuoğlu’nu tayin etti.
Alsancak Mustafa Denizli Stadı’ndaki zorlu mücadelede Aksuoğlu’nun yardımcılıklarını Burak Cansız ve Mehmet Şengül yapacak. Karşılaşmanın 4. Hakemi Metehan Alpat olacak.
İkinci kez Erzurumspor’un maçını yönetecek olan Furkan Aksuoğlu, 2021-2022 sezonunda Dadaşların, Denizlispor’u 3-1 mağlup ettiği maçı yönetmişti.
Muhammet TARHAN/PUSULA
Spor Toto 1. Ligin 10’ncu haftasında oynanacak olan maçların hakemleri belli oldu.
Türkiye Futbol Federasyonu (TFF) Merkez Hakem Kurulu(MHK) Erzurumspor’un yarın saat 16:00’da deplasmanda oynayacağı Altay maçına orta hakem olarak Furkan Aksuoğlu’nu tayin etti.
Alsancak Mustafa Denizli Stadı’ndaki zorlu mücadelede Aksuoğlu’nun yardımcılıklarını Burak Cansız ve Mehmet Şengül yapacak. Karşılaşmanın 4. Hakemi Metehan Alpat olacak.
İkinci kez Erzurumspor’un maçını yönetecek olan Furkan Aksuoğlu, 2021-2022 sezonunda Dadaşların, Denizlispor’u 3-1 mağlup ettiği maçı yönetmişti.